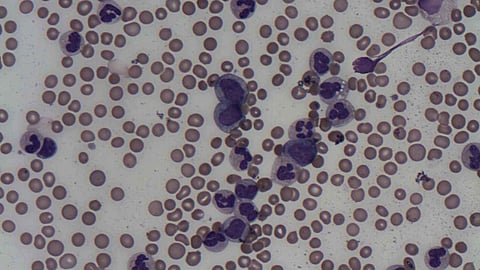

HOUSTON ― According to researchers at The University of Texas MD Anderson Cancer Center, 80% of patients with previously untreated or relapsed/refractory advanced-phase chronic myeloid leukemia (CML) – including both accelerated or myeloid blast phases of the disease – or Philadelphia chromosome-positive acute myeloid leukemia (AML) achieved a bone marrow remission when treated with a novel combination of decitabine, venetoclax and ponatinib.
Findings from the Phase II clinical trial, published today in The Lancet Haematology, represent an important step forward for patients with advanced-phase CML, who tend to have poor outcomes. Limited data on a standard-of-care approach to treating the disease, highlights the need for investigations into additional therapeutics.
Over the last decade, there have been very few studies that evaluated a regimen to treat this rare disease and identify a potential standard-of-care treatment.
Nicholas Short, M.D.
“Over the last decade, there have been very few studies that evaluated a regimen to treat this rare disease and identify a potential standard-of-care treatment,” said principal investigator principal investigator Nicholas Short, M.D., associate professor of Leukemia. . “It is important that we get these patients into a state of marrow remission as this will allow them to be considered for a stem cell transplant. We were able to achieve this response in 80% of patients on this trial.”
A total of 20 patients were enrolled in the trial, with 14 having myeloid blast-phase CML, four with accelerated-phase CML, and two with Philadelphia chromosome-positive AML. Overall, 50% of patients achieved a complete remission or complete remission with an incomplete hematological recovery, and an additional 30% of patients achieved a morphologic leukemia-free state. Responses were seen even in patients who had received multiple prior therapies and in those with high-risk cytogenetic or molecular features.
“For this trial, we were able to build on previous preclinical and clinical research conducted at MD Anderson, which identified synergy between the BCL-2 inhibitor, venetoclax and the BCR::ABL1 tyrosine kinase inhibitor, ponatinib,” Short said. “This knowledge led us to consider this novel treatment regimen for this aggressive disease.”
The researchers observed expected side effects, which were consistent with previous studies with the drugs. Common side effects included neutropenia, rash and nausea.
The trial is ongoing and enrolling additional patients. MD Anderson researchers also are conducting additional studies building on the approach of adding targeted therapies into new combinations for patients with advanced-phase CML.
The trial was funded by Takeda Oncology, the National Institutes of Health and the National Cancer Institute Cancer Center Support Grant (P30 CA016672).
Newswise/SJH